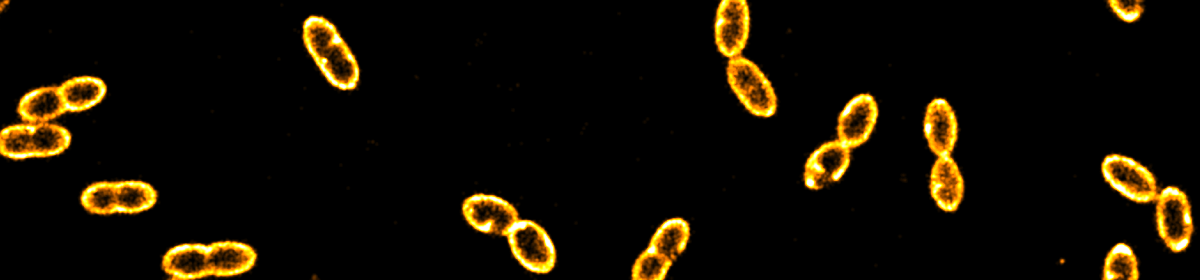

Welcome to the chair group of Biosensorics
At the chair group of Biosensorics, we develop and apply cutting-edge technologies to address fundamental and applied questions in the life sciences. Led by Prof. Dr. Johannes Hohlbein, our research sits at the intersection of advanced microscopy, molecular biophysics, and biotechnology.
Our core expertise lies in single-molecule fluorescence and single-cell techniques, including single-molecule Förster resonance energy transfer (smFRET), super-resolution microscopy (STORM, PALM), microfluidics, and single-particle tracking. These methods allow us to observe individual biomolecules in action - capturing conformational changes, binding events, and molecular interactions that are invisible to conventional approaches. By pushing the boundaries of what fluorescence imaging can reveal, we gain mechanistic insights at a level of detail that ensemble measurements simply cannot provide.
A central pillar of our work is live-cell imaging. Using photo-activated localisation microscopy and related techniques, we follow the behaviour of proteins and CRISPR-Cas complexes directly inside living bacterial cells, observing how molecular search processes unfold in the crowded environment of the bacterial nucleoid. Beyond fundamental biology, we translate our microscopy platforms into biotechnological applications - from probing DNA-polymerase interactions relevant to genome maintenance, to characterising food-relevant biomolecular assemblies and bacteria. Our technology-driven approach bridges spatiotemporal scales from nanometres to micrometres and from milliseconds to hours.
We are strongly committed to open science: custom-built platforms such as the miCube microscope are openly shared with the community, reflecting our belief that accessible instrumentation and software accelerates discovery.
Sounds interesting? Get in touch!
